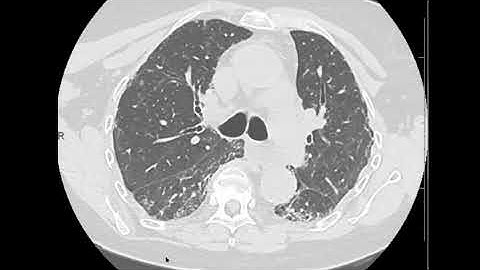
UIP evolution from NSIP on CT

⬇ DOWNLOAD NOW
Kalau muncul iklan pop-up, tutup lalu klik tombol kembali
Download lagu Nonspecific interstitial pneumonia (NSIP): multiple examples with typical imaging patterns secara gratis hanya untuk keperluan promosi. Dukung artis favorit kamu dengan membeli musik original di iTunes atau platform resmi lainnya.
 Pathology Insights: Nonspecific Interstitial Pneumonia (NSIP) with Sanjay Mukhopadhyay, MD
Pathology Insights: Nonspecific Interstitial Pneumonia (NSIP) with Sanjay Mukhopadhyay, MD
 High Yield Pulmonary Case #2 Nonspecific interstitial pneumonia
High Yield Pulmonary Case #2 Nonspecific interstitial pneumonia
 CT assessment - "propeller pattern" seen with UIP (usual interstitial pneumonia) from IPF
CT assessment - "propeller pattern" seen with UIP (usual interstitial pneumonia) from IPF
 Usual Interstitial Pneumonia (UIP)
Usual Interstitial Pneumonia (UIP)
 ILD: Organizing the Findings
ILD: Organizing the Findings
UIP evolution from NSIP on CT
UIP evolution from NSIP on CT
 Idiopathic Interstitial Pneumonias
Idiopathic Interstitial Pneumonias
 NON SPECIFIC INTERSTITIAL PNEUMONIA, NSIP
NON SPECIFIC INTERSTITIAL PNEUMONIA, NSIP